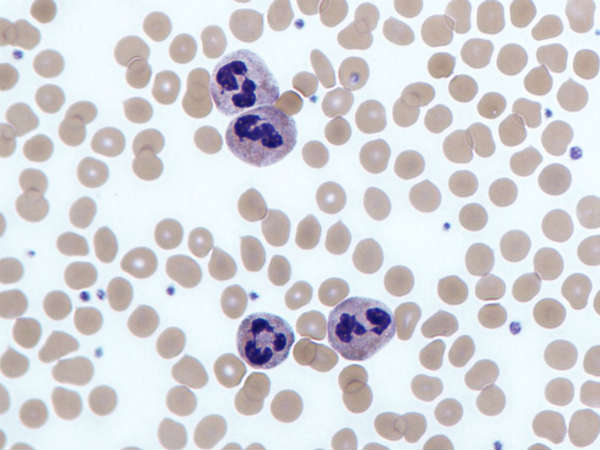

Latest Updates
-
అన్నం, పప్పు,పరాఠా, రోటీల్లోకి బెస్ట్ కాంబినేషన్..రాజస్థానీ స్పెషల్ వెల్లుల్లి ఎర్ర మిరప చట్నీ -
ఉగాది స్పెషల్..ఇంట్లోనే రెస్టారెంట్ స్టైల్ క్రంచీ బేబీ కార్న్ 65..వాహ్ అనిపించే బెస్ట్ స్టార్టర్! -
గుంటూరు కారం పొడి, చిట్టి ఇడ్లీ..ఇలా చేస్తే ప్లేట్లు ఖాళీ అవ్వాల్సిందే! -
నో గ్యాస్, నో స్టవ్.. నిమిషాల్లో తయారయ్యే కమ్మని పల్లెటూరి రోటి పెరుగు పచ్చడి..ప్లేట్ అన్నం ఖాళీ అవ్వాల్సిందే! -
రోజూ తినే పప్పు బోర్ కొట్టిందా? అయితే ఈ ధాబా స్టైల్ దాల్ తడ్కా ట్రై చేయండి..గిన్నెలు గిన్నెలు లేపేస్తారు! -
తెలుగువారి తొలి పండుగ: ఉగాది 2026 తేదీ, పేరు, ఆచారాలు, సంప్రదాయాలు -
కేవలం 10 నిమిషాల్లో దూదిలాంటి టమాటో సెట్ దోశ.. పప్పు నానబెట్టే పనే లేదు..బరువు తగ్గాలనుకునే వారికి బెస్ట్! -
భాగస్వామి సంతృప్తిలో అట్టడుగు స్థానంలో భారత్..మూసిన తలుపుల వెనుక అసలు కథ! -
ఉగాది స్పెషల్ నేతి బొబ్బట్లు.. ఇలా చేస్తే పర్ఫెక్ట్ గా వస్తాయి..నోట్లో వేసుకోగానే వెన్నలా కరిగిపోతూ అమృతమే! -
పండిన అరటిపండ్లతో సింపుల్ అండ్ సూపర్ స్వీట్..హెల్తీ బనానా బర్ఫీ ఎలా చేసుకోవాలంటే..
తెల్ల రక్తకణాలు హెచ్చు స్థాయిలో ఉంటే ఏమి జరుగుతుంది?
న్యూట్రోఫిల్స్, మీ శరీరం అంటువ్యాధులతో పోరాడటానికి ఉపయోగపడే ఒక రకమైన తెల్ల రక్త కణం. న్యూట్రోఫిల్ స్థాయి ఎక్కువగా ఉండటం అనేది అంటువ్యాధి సంక్రమణ వలన కలుగుతుంది, కానీ ఇతర వైద్య పరిస్థితులు మరియు కొన్ని మందులు వలన కూడా వీటి స్థాయి పెరుగుతుంది.
శారీరక లేదా మానసిక ఒత్తిడి, మరియు ధూమపానం కూడా న్యూట్రోఫిల్ స్థాయిలను పెంచుతాయి. న్యూట్రోఫిల్ స్థాయిలు ఎక్కువగా ఉండటం అన్నది సాధారణంగా తీవ్రమైన సమస్య కాదు, అయితే మీలో న్యూట్రోఫిల్ స్థాయి అధికంగా లేదా వీటి కౌంట్ ఎక్కువగా ఉన్నది అని తెలుసుకుంటే, మీరు డాక్టర్ ను సంప్రదించాలి.
న్యూట్రోఫిల్ స్థాయిలు ఎక్కువగా ఉంటే తరువాత తీసుకోవలసిన సాధారణ స్టెప్స్
న్యూట్రోఫిల్ స్థాయిలు అధికంగా ఉండటం విడిగా చూస్తె సాధారణంగా ప్రమాదకరం కాదని పరిగణిస్తారు. చాలా సందర్భాలలోఈ స్థాయిలు చివరికి వాటంతటవే తిరిగి సాధారణ స్థాయికి చేరుకుంటాయి మరియు దీనికి ఏ చికిత్స అవసరం లేదు. మీ న్యూట్రోఫిల్ స్థాయిలు సాధారణ స్థాయికి తిరిగి చేరుకున్నాయి అని తెలిసేవరకు మీ వైద్యుడు మిమ్మలిని రక్త పరీక్షలు చేయించుకోవాలని సిఫార్సు చేయటానికి చాలా అవకాశం ఉంది.
మీ డాక్టర్ తో సంప్రదించండి
మీ న్యూట్రోఫిల్ స్థాయిలు అధికంగా ఉంటే, మీ డాక్టర్ మీ వైద్య చరిత్ర గురించి అడిగే అవకాశం ఉన్నది. మీరు తీసుకుంటున్నమందుల గురించి డాక్టరుకు దాచకుండా చెప్పాలి. స్టెరాయిడ్స్ ప్రత్యేకంగా మీ న్యూట్రోఫిల్ స్థాయిలను పెంచే అవకాశం ఉన్నది. మీరు ఇటీవల కాలంలో అనారోగ్యం పాలయి ఉంటే, ఆ విషయం గురించి డాక్టరుతో చెప్పాలి లేదా మీరు ఏ ఇతర భౌతిక లేదా మానసిక ఒత్తిడితో బాధపడుతున్నట్లయితే ఆ విషయాన్ని కూడా డాక్టరుతో బహిర్గతం చేయాలి. మీ ఉదయం చేయించుకునే రక్తపరీక్ష కూడా మీ న్యూట్రోఫిల్ స్థాయి పెరగటానికి కారణమవుతుంది. గర్భం ధరించటం లేదా అంటువ్యాధి ఏదైనా సోకటం లేదా ఏ రకమైన శారీరక గాయం కూడా మీ న్యూట్రోఫిల్ స్థాయిలను పెంచుతుంది. ఒకవేళ మీరు ధూమపానం చేసేవారు అయి ఉంటే, మీ డాక్టర్ దానిని మానేయమని చెపుతారు.
అదనపు పరీక్షలు
ఈ ఘనమైన న్యూట్రోఫిల్స్ కౌంట్ చూడటానికి రక్త పరీక్షలు కొనసాగిస్తున్నట్లయితే లేదా మీ డాక్టర్ అధిక న్యూట్రోఫిల్ స్థాయికి మీ అంతర్లీన పరిస్థితి అని అనుమానించినప్పుడు లేదా, ఆమె మీ న్యూట్రోఫిల్ స్థాయిలు అధికంగా ఎందుకు అని అర్థం చేసుకోవటానికి తదుపరి పరీక్షలు సిఫారసు చేయవచ్చు. వివిధ అంటువ్యాధులు, తాపజనక పరిస్థితులు, మరియు కొన్నిరకాల క్యాన్సర్ వ్యాధికి ప్రత్యేక రక్త పరీక్షలు చేయిస్తారు.
అధిక స్థాయిలో ఉన్న న్యూట్రోఫిల్స్ పర్యవేక్షణ మరియు చికిత్స
అంతర్లీన వ్యాధి ఉన్నట్లు నిర్ధారణ అయితే, దానివలన అధిక న్యూట్రోఫిల్ స్థాయిలు ఉంటే, దీనికి చికిత్స ఈ పరిస్థితి మీద ఆధారపడి చేయబడుతుంది. మీ న్యూట్రోఫిల్ స్థాయిలు అధికంగా ఉండటానికి స్పష్టమైన కారణం లేకుంటే, మీ డాక్టర్ న్యూట్రోఫిల్ స్థాయిలను తెలుసుకోవటానికి అప్పుడప్పుడు రక్త పరీక్షలు చేయించుకోవటానికి సిఫార్సు చేస్టారు.
Disclaimer: ఈ ఆర్టికల్ లో అందించిన సమాచారం సాధారణ సమాచారం,విద్యా ప్రయోజనాల కోసం మాత్రమే. ఇది వృత్తిపరమైన వైద్య సలహా, రోగ నిర్ధారణ లేదా ట్రీట్మెంట్ కు ప్రత్యామ్నాయంగా ఉద్దేశించబడలేదు. వైద్య పరిస్థితికి సంబంధించి మీకు ఏవైనా ప్రశ్నలు ఉంటే మీ డాక్టర్ లేదా సంబంధిత నిపుణుల సలహా తీసుకోండి.



Click it and Unblock the Notifications











